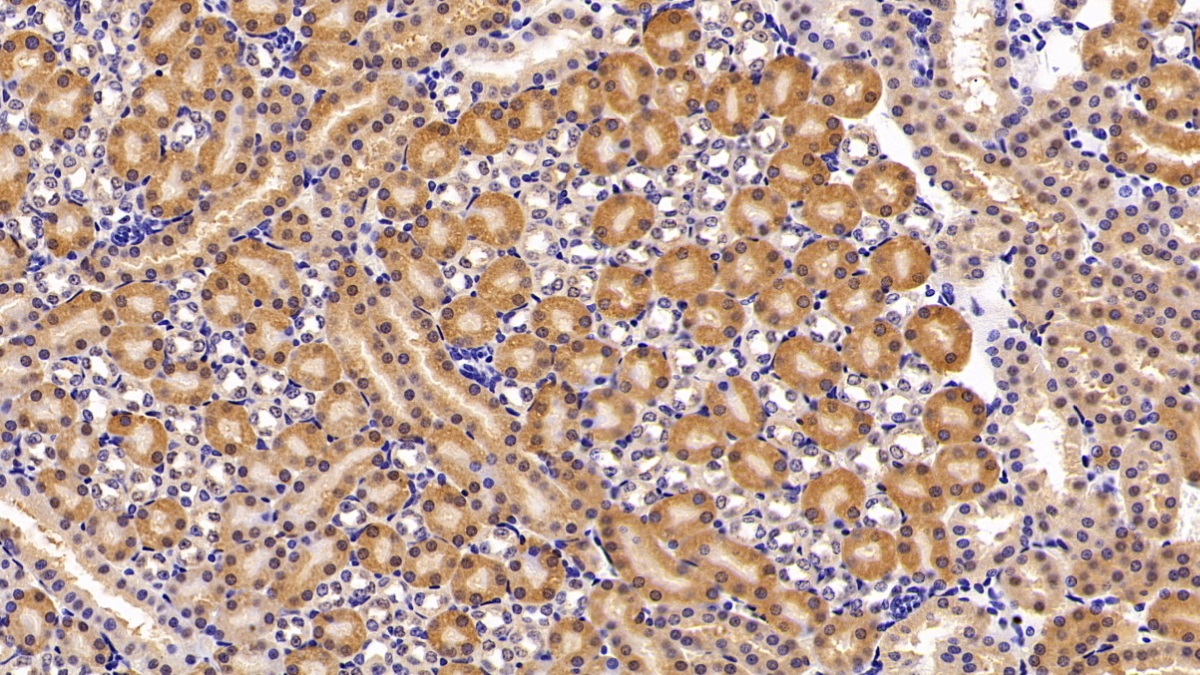

Polyclonal Antibody to Heme Oxygenase 1 (HO1)
HMOX1; Hsp32; HMOX1D
- Product No.PAA584Mu01
- Organism SpeciesMus musculus (Mouse) Same name, Different species.
- SourcePolyclonal antibody preparation
- HostRabbit
- Potencyn/a
- Ig Type IgG
- PurificationAntigen-specific affinity chromatography followed by Protein A affinity chromatography
- LabelNone
- Immunogen RPA584Mu01-Recombinant Heme Oxygenase 1 (HO1)
- Buffer FormulationPBS, pH7.4, containing 0.02% NaN3, 50% glycerol.
- TraitsLiquid
- Concentration0.41mg/mL
- Organism Species Moren/a
- ApplicationsWB; IHC
If the antibody is used in flow cytometry, please check FCM antibodies. - DownloadInstruction Manual
- UOM 20µl100µl 200µl 1ml 10ml
- FOB
US$ 97
US$ 227
US$ 324
US$ 810
US$ 3240
For more details, please contact local distributors!
SPECIFITY
The antibody is a rabbit polyclonal antibody raised against HO1. It has been selected for its ability to recognize HO1 in immunohistochemical staining and western blotting.
USAGE
Western blotting: 0.01-2µg/mL;
Immunohistochemistry: 5-20µg/mL;
Optimal working dilutions must be determined by end user.
STORAGE
Store at 4°C for frequent use. Stored at -20°C in a manual defrost freezer for two year without detectable loss of activity. Avoid repeated freeze-thaw cycles.
STABILITY
The thermal stability is described by the loss rate. The loss rate was determined by accelerated thermal degradation test, that is, incubate the protein at 37°C for 48h, and no obvious degradation and precipitation were observed. The loss rate is less than 5% within the expiration date under appropriate storage condition.
GIVEAWAYS
INCREMENT SERVICES
-
 Antibody Labeling Customized Service
Antibody Labeling Customized Service
-
 Protein A/G Purification Column
Protein A/G Purification Column
-
 Staining Solution for Cells and Tissue
Staining Solution for Cells and Tissue
-
 Positive Control for Antibody
Positive Control for Antibody
-
 Tissue/Sections Customized Service
Tissue/Sections Customized Service
-
 Phosphorylated Antibody Customized Service
Phosphorylated Antibody Customized Service
-
 Western Blot (WB) Experiment Service
Western Blot (WB) Experiment Service
-
 Immunohistochemistry (IHC) Experiment Service
Immunohistochemistry (IHC) Experiment Service
-
 Immunocytochemistry (ICC) Experiment Service
Immunocytochemistry (ICC) Experiment Service
-
 Flow Cytometry (FCM) Experiment Service
Flow Cytometry (FCM) Experiment Service
-
 Immunoprecipitation (IP) Experiment Service
Immunoprecipitation (IP) Experiment Service
-
 Immunofluorescence (IF) Experiment Service
Immunofluorescence (IF) Experiment Service
-
 Buffer
Buffer
-
 DAB Chromogen Kit
DAB Chromogen Kit
-
 SABC Kit
SABC Kit
-
 Long-arm Biotin Labeling Kit
Long-arm Biotin Labeling Kit
-
 Real Time PCR Experimental Service
Real Time PCR Experimental Service
| Magazine | Citations |
| The American Journal of Pathology | Characterization of the Intrarenal Renin-Angiotensin System in Experimental Alport Syndrome PubMed: 25777063 |
| BioMed Research International | Serum Heme Oxygenase-1 and BMP-7 Are Potential Biomarkers for Bone Metabolism in Patients with Rheumatoid Arthritis and Ankylosing Spondylitis Pubmed:27314037 |
| Cancer Medicine | Circulating CD14+HLA-DR-/low myeloid-derived suppressor cells in leukemia patients with allogeneic hematopoietic stem cell transplantation: novel clinical potential strategies for the prevention and cellular therapy of graft-versus-host disease Pubmed:27109254 |
| Redox Report: Communications in Free Radical Research | Decreased expression of heme oxygenase is associated with depressive symptoms and may contribute to depressive and hypertensive comorbidity Pubmed:26824276 |
| Canadian Journal of Physiology and Pharmacology | Sulforaphane protects against sodium valproate–induced acute liver injury pubmed:28112972 |
| Peptides. | Carnosine ameliorates cognitive deficits in streptozotocin-induced diabetic rats: Possible involved mechanisms. pubmed:27777064 |
| european journal of pharmacology | S-allyl cysteine ameliorates cognitive deficits in streptozotocin-diabetic rats via suppression of oxidative stress, inflammation, and acetylcholinesterase. pubmed:27887948 |
| brain research | Ellagic acid exerts protective effect in intrastriatal 6-hydroxydopamine rat model of Parkinson's disease: Possible involvement of ERβ/Nrf2/HO-1 signaling. pubmed:28238669 |
| biomedicine & pharmacotherapy | Citrus leaf extract reduces blood pressure and vascular damage in repeatedly heated palm oil diet-Induced hypertensive rats. pubmed:28068636 |
| Inflammopharmacology. | Implication of Nrf2/HO-1 pathway in the coloprotective effect of coenzyme Q10 against experimentally induced ulcerative colitis. pubmed:28050757 |
| Environmental Toxicology and Pharmacology | Ameliorative potential of linagliptin and/or calcipotriol on bleomycin-induced lung fibrosis: In vivo and in vitro study pubmed:28192751 |
| Journal of Microbiology, Immunology and Infection | Identification of a panel of serum protein markers in early stage of sepsis and its validation in a cohort of patients pubmed:28655573 |
| Nutrition & Metabolism | Hepatic, adipocyte, enteric and pancreatic hormones: response to dietary macronutrient composition and relationship with metabolism pubmed:28694840 |
| Biomedicine & Pharmacotherapy | Ameliorative potential of sitagliptin and/or resveratrol on experimentallyinduced clear cell renal cell carcinoma pubmed:29101811 |
| Acta Paediatrica | Serum complement factor 5a levels are associated with nonalcoholic fatty liver disease in obese children DOI: 10.1111/apa.14106 |
| Naunyn-Schmiedeberg's Arch Pharmacol | Quercetin and tin protoporphyrin attenuate hepatic ischemia reperfusion injury: role of HO-1 pubmed:28589248 |
| Asian Pacific Journal of Cancer Prevention | Ameliorative Effect of Coenzyme Q10 and/or Candesartan on Carboplatin-Induced Nephrotoxicity: Roles of Apoptosis, Transforming Growth Factor-Β1, Nuclear Factor Kappa-B And The Nrf2/HO-1 Pathway pubmed:28670881 |
| Biomedicine & pharmacotherapy | Berberine ameliorates intrahippocampal kainate-induced status epilepticus and consequent epileptogenic process in the rat: Underlying mechanisms pubmed:28061403 |
| Talanta | Simultaneous accurate quantification of HO-1, CD39, and CD73 in human calcified aortic valves using multiple enzyme digestion–filter aided sample pretreatment … 10.1016:j.talanta.2018.01.044 |
| Pharmacological Reports | The Association between Inflammatory Markers (iNOS, HO-1, IL-33, MIP-1β) and Depression with and without Posttraumatic Stress Disorder 10.1016:j.pharep.2018.06.001 |
| Physiology & Behavior | Linagliptin potentiates the effect of l-dopa on the behavioural, biochemical and immunohistochemical changes in experimentally-induced Parkinsonism: Role of toll … Pubmed:29410018 |
| Journal of Infection and Chemotherapy | Targeting the proinflammatory cytokines, oxidative stress, apoptosis and TGF-β1/STAT-3 signaling by irbesartan to ameliorate doxorubicin-induced hepatotoxicity Pubmed:29753615 |
| American Institute of Physics | Anti-hemolytic and anti-inflammatory activities of the methanolic extract of (P.Beauv.) Briq. leaves in 2-butoxyethanol-hemolytic induced … 10.1063:1.5033415 |
| Iranian Journal of Basic Medical Sciences | Tempol relieves lung injury in a rat model of chronic intermittent hypoxia via suppression of inflammation and oxidative stress Doi: 10.22038/IJBMS.2018.31716.7714 |
| Biomedicine & Pharmacotherapy | Targeting Nrf2/HO-1 signaling by crocin: Role in attenuation of AA-induced ulcerative colitis in rats Pubmed: 30530041 |
| Experimental Parasitology | Sodium arsenite augments sensitivity of Echinococcus granulosus protoscoleces to albendazole Pubmed: 30790573 |
| JGH OPEN | Cilostazol against 2, 4, 6‐trinitrobenzene sulfonic acid‐induced colitis: Effect on tight junction, inflammation, and apoptosis |
| Journal of Food Biochemistry | Vanillic acid alleviates palmitic acid‐induced oxidative stress in human umbilical vein endothelial cells via Adenosine Monophosphate‐Activated Protein Kinase … |
| Experimental and Therapeutic Medicine | Effect of heme oxygenase 1 and renin/prorenin receptor on oxidized low‑density lipoprotein‑induced human umbilical vein endothelial cells |
| Life Sciences | Crocin attenuates lung inflammation and pulmonary vascular dysfunction in a rat model of bleomycin-induced pulmonary fibrosis Pubmed: 31465731 |
| Respiratory physiology & neurobiology | Targeting oxidative stress, proinflammatory cytokines, apoptosis and toll like receptor 4 by empagliflozin to ameliorate bleomycin-induced lung fibrosis Pubmed: 31600583 |
| Life Sci | The protective effect of Lactobacillus versus 5-aminosalicylic acid in ulcerative colitis model by modulation of gut microbiota and Nrf2/Ho-1 pathway Pubmed: 32526285 |
| JAMA Surgery | Intraoperative dexmedetomidine for prevention of postoperative delirium in elderly patients with mild cognitive impairment Pubmed: 28593326 |
| JOURNAL OF PHARMACY AND PHARMACOLOGY | Isoliquiritigenin attenuates inflammation and modulates Nrf2/caspase-3 signalling in STZ-induced aortic injury 33793806 |
| Exp Parasitol | In vitro protoscolicidal effects of lithocholic acid on protoscoleces of Echinococcus granulosus and its mechanism Pubmed:35594934 |
| Free Radical Biology and Medicine | Flavonoid 4, 4′-dimethoxychalcone induced ferroptosis in cancer cells by synergistically activating Keap1/Nrf2/HMOX1 pathway and inhibiting FECH Pubmed:35697292 |
| Catalog No. | Related products for research use of Mus musculus (Mouse) Organism species | Applications (RESEARCH USE ONLY!) |
| RPA584Mu01 | Recombinant Heme Oxygenase 1 (HO1) | Positive Control; Immunogen; SDS-PAGE; WB. |
| EPA584Mu62 | Eukaryotic Heme Oxygenase 1 (HO1) | Positive Control; Immunogen; SDS-PAGE; WB. |
| RPA584Mu02 | Recombinant Heme Oxygenase 1 (HO1) | Positive Control; Immunogen; SDS-PAGE; WB. |
| EPA584Mu61 | Eukaryotic Heme Oxygenase 1 (HO1) | Positive Control; Immunogen; SDS-PAGE; WB. |
| APA584Mu61 | Active Heme Oxygenase 1 (HO1) | Cell culture; Activity Assays. |
| PAA584Mu02 | Polyclonal Antibody to Heme Oxygenase 1 (HO1) | WB; IHC; ICC; IP. |
| PAA584Mu01 | Polyclonal Antibody to Heme Oxygenase 1 (HO1) | WB; IHC |
| LAA584Mu71 | Biotin-Linked Polyclonal Antibody to Heme Oxygenase 1 (HO1) | WB |
| SEA584Mu | ELISA Kit for Heme Oxygenase 1 (HO1) | Enzyme-linked immunosorbent assay for Antigen Detection. |
| LMA584Mu | Multiplex Assay Kit for Heme Oxygenase 1 (HO1) ,etc. by FLIA (Flow Luminescence Immunoassay) | FLIA Kit for Antigen Detection. |